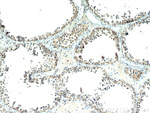
KTN1 Antibody in Immunohistochemistry (Paraffin) (IHC (P))

Search
Proteintech
KTN1 Polyclonal Antibody
{{$productOrderCtrl.translations['antibody.pdp.commerceCard.promotion.promotions']}}
{{$productOrderCtrl.translations['antibody.pdp.commerceCard.promotion.viewpromo']}}
{{$productOrderCtrl.translations['antibody.pdp.commerceCard.promotion.promocode']}}: {{promo.promoCode}} {{promo.promoTitle}} {{promo.promoDescription}}. {{$productOrderCtrl.translations['antibody.pdp.commerceCard.promotion.learnmore']}}
产品信息
19841-1-AP
种属反应
已发表种属
宿主/亚型
分类
类型
抗原
偶联物
形式
浓度
规格
纯化类型
保存液
内含物
保存条件
运输条件
产品详细信息
This antibody reacts with normal gastrointestinal epithelium as well as gastrointestinal and breast tumors, resulting in a cytoplasmic staining pattern.
Immunogen sequence: KSQIEQLKQ QNYQQASSFP PHEELLKVIS EREKEISGLW NELDSLKDAV EHQRKKNNDL REKNWEAMEA LASTEKMLQD KVNKTSKERQ QQVEAVELEA KEVLKKLFPK VSVPSNLSYG EWLHGFEKKA KECMAGTSGS EEVKVLEHKL KEADEMHTLL QLECEKYKSV LAETEGILQK LQRSVEQEEN KWKVKVDESH KTIKQMQSSF TSSEQELERL RSENKDIENL RREREHLEME LEKAEMERST YVTEVRELKA QLNETLTKLR TEQNERQKVA GDLHKAQQSL ELIQSKIVKA AGDTTVIENS DVSPETESSE KETMSVSLNQ TVTQLQQLLQ AVNQQLTKEK EHYQVLE (951-1307 aa encoded by BC117132)
靶标信息
Various cellular organelles and vesicles are transported along the microtubules in the cytoplasm. Likewise, membrane recycling of the endoplasmic reticulum (ER), Golgi assembly at the microtubule organizing center, and alignment of lysosomes along microtubules are all related processes. The transport of organelles requires a special class of microtubule-associated proteins (MAPs). One of these is the molecular motor kinesin an ATPase that moves vesicles unidirectionally toward the plus end of the microtubule. Another such MAP is kinectin, a large integral ER membrane protein. Antibodies directed against kinectin have been shown to inhibit its binding to kinesin.
仅用于科研。不用于诊断过程。未经明确授权不得转售。
生物信息学
蛋白别名: CG-1 antigen; CG1 protein; KIAA0004; Kinectin; Kinesin receptor; ktn1; SEREX-defined hypothetical rhabdomyosarcoma antigen; unnamed protein product
基因别名: CG1; KIAA0004; KNT; KTN1; MU-RMS-40.19
UniProt ID: (Human) Q86UP2, (Mouse) Q61595
Entrez Gene ID: (Human) 3895, (Mouse) 16709